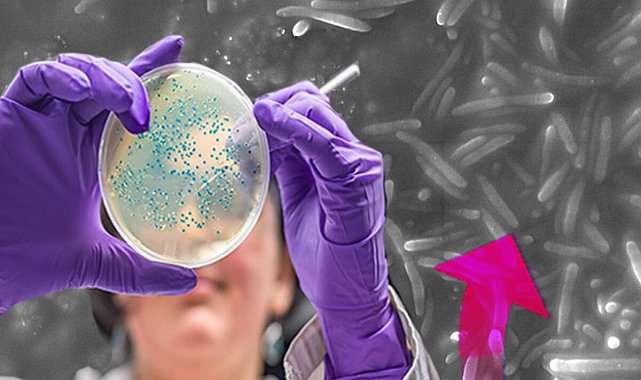

Türk bilim insanlarından umut verici keşif! Çevre kirliliğine karşı savaşta silah olabilecek yeni bir bakteri bulundu | 7 SORU 7 YANIT
Genel
22.12.2022 - 17:08, Güncelleme:
22.12.2022 - 17:08
Türk bilim insanlarından umut verici keşif! Çevre kirliliğine karşı savaşta silah olabilecek yeni bir bakteri bulundu | 7 SORU 7 YANIT
Türk bilim insanları, Antarktika’da bulunan Ardley Adası’ndan alınmış göl suyu numunesinde yeni bir bakteri türü tanımladı.
İnsanlar, tarih boyunca bakteri ve virüslerle birlikte yaşadı; yaşamaya da devam ediyor.
İklim değişikliği sonucunda binlerce yıldır donmuş topraklar ve buzullar erimeye başladığı için bugün eski virüs ve bakterilerin yeniden canlanması ya da adı daha önce duyulmamış bakterilerin ortaya çıkma ihtimali oldukça yüksek. Bu nedenle dünyadaki pek çok bilim insanı kutuplarda araştırmalar yapıyor.
Son olarak Samsun Ondokuz Mayıs Üniversitesi’nden Doç. Dr. Aslıhan Kurt Kızıldoğan ve doktora öğrencisi Çiğdem Otur ile Hacettepe Üniversitesi’nden Doç. Dr. Sezer Okay, Antarktika’daki Ardley Adası’ndan alınmış olan göl suyu numunesinde yeni bir bakteri türü tanımladı.
Bakteriye 2015 yılında Nobel Kimya Ödülü’nü alan Prof. Dr. Aziz Sancar‘ın adı verildi.
Biz dünya üzerindeki bakteri ve virüslerin yol açtığı bazı hastalıklara karşı biz bağışıklık geliştirirken onlar da yeni bulaşma yöntemleri bulmayı sürdürüyor. Örneğin yüz yıl kadar önce İskoç bakteriyolog Alexander Fleming, ilk antibiyotiği (penisilin) bulduğundan beri tedavi amaçlı antibiyotik kullanıyoruz. Buna karşılık bakteriler de antibiyotiğe karşı direnç geliştirecek şekilde evrimleşiyor.
KİRLETİCİLERİN BULUNDUĞU ORTAMLARDA KULLANILABİLİR
Bakterinin DNA’sını analiz ettiklerinde pek çok şeye direnç sağladığını bulduklarını söyleyen Doç. Dr. Okay, şu detayların altını çizdi:
-- İzole ettiğimiz bakterinin canlı yaşamı için olumsuz şartlara dayanıklılık sağlayan genlere sahip olduğunu gördük. Soğuk ortamda protein üreten genleri bulunuyor. Dahası farklı miktarda dizel yakıt içeren ortamlarda bakterinin gelişimini incelediğimizde yüzde 5 oranında dizeli parçalayabildiğini de tespit ettik.
-- Ayrıca birçok antibiyotiğe karşı dirençte rol alan çok sayıda geni de barındırıyor. Özetle tanımladığımız bu yeni tür, ağır metal ve hidrokarbon gibi kirleticilerin bulunduğu ortamlarda yüksek sıcaklık istemeden kullanılabilecek.
Peki, bu bakteri nasıl keşfedildi? Bundan sonraki süreçte nasıl adımların atılması bekleniyor? Konuyu çalışmayı yürüten üç uzmanla masaya yatırdık.
KUTUPLARDAKİ BAKTERİLER İLERİSİ İÇİN HANGİ MESAJLARI VERİYOR?
1-) Son yıllarda Antarktika'dan getirilen örnekler üzerinde yapılan araştırmaların sayısı arttı. İki yıl kadar önce yine bir grup Türk bilim insanı, tarım alanında kullanılabilecek bir bakteri türü keşfettiklerini duyurmuştu. Şimdi de siz yeni bir bakteri türünü tanımladınız. Antarktika’daki bu çalışmalar ve ortaya çıkan bakterileri nasıl yorumlamak gerekiyor?
Doç. Dr. Aslıhan Kurt Kızıldoğan: Antarktika’ya yapılan seferlerde Türkiye Bilimsel ve Teknolojik Araştırma Kurumu (TÜBİTAK) tarafından desteklenen fiziki bilimler, canlı bilimleri, sosyal bilimler ve yer bilimleri gibi alanlarda çok çeşitli çalışmalar yürütülüyor.
Bu çalışmalar kapsamında; buzul değişiminin izlenmesi, küresel iklim değişikliğinin izlenmesi, kıyı çizgisinin belirlenmesi gibi araştırmaların yanı sıra deniz canlıları ve mikroorganizmalar gibi o bölgenin biyoçeşitliliğini araştıran projeler de yapılıyor. Biyoçeşitlilik çalışmaları kapsamında izole edilmiş bakteriler var. Bu bakterilerin öne çıkan özelliklerini ortaya çıkararak bu özelliklerden faydalanmaya çalışıyoruz.
2020’de İTÜ Kutup Araştırmaları Uygulama ve Araştırma Merkezi öncülüğünde de bir bakteri tanımlandı. Arktik'ten getirilen örnekler üzerinde yapılan çalışmada amaçlanan; tarımda yaygın kullanılan ve toprak kirlenmesine neden olan zehirli kimyasal bir maddeyi daha az zararlı hale getiren bir bakterilerin tanımlanmasıydı… Başarılı bir sonuç alındı. Tarımsal üretimde istenmeyen bitkileri yok etmek için kullanılacak bir bakteri türü ortaya çıkarıldı.
BAKTERİYLE İLGİLİ ÇALIŞMALAR NE ZAMAN BAŞLADI?
2-) Bakterinin keşif süreci nasıl gelişti?
Doç. Dr. Aslıhan Kurt Kızıldoğan: Ocak-Mart 2019 tarihlerinde gerçekleştirilen üçüncü Türk Antarktika Seferi’ne katılan Karadeniz Teknik Üniversitesi’nden Prof. Dr. Ersan Başar, farklı projelerden araştırmacılar için numuneleri temin etti ve bu numunelerden ilgili olanları Ondokuz Mayıs Üniversitesi’ne iletti. Ardından da çalışmalara dahil olduk.
BULUNAN BAKTERİ HANGİ TÜRE AİT?
3-) Bakterinin türü tam olarak nedir?
Doç. Dr. Sezer Okay: Tür olarak ‘Flavobacterium’ cinsine benziyor. Flavobakteriler, toprakta ya da sularda bulunan ve bazı türleri tatlı su balıklarında hastalığa sebep olan bir bakteri sınıfı. Ancak insanlara üzerinde bilinen bir zararları yok.
Bizim izole ettiğimiz bakteri üzerinde yaptığımız genetik ve biyokimyasal testler bu bakterinin Flavobacterium cinsine ait olduğunu ancak bu cins içinde şu ana kadar tanımlanmış türlerden farklılıklar gösterdiğini ortaya koydu. Tür gruplaması daha spesifik bir tanımlama olduğu için aynı türe ait olan canlıların daha büyük oranda birbirine benzemesi gerekiyor. Bizim izole ettiğimiz bakteriye tür düzeyinde benzeyen başka bir tür olmadığını tespit ettik.
Bakterinin taramalı elektron mikroskobu görüntüsü...
ÇALIŞMA NASIL İLERLEDİ?
4-) Araştırmanızda hangi aşamalardan geçerek bu sonuca ulaşıldı?
Doç. Dr. Sezer Okay: Bakterilerin üremesi için kullandığımız çeşitli besin ortamları bulunuyor. Göl suyu numunesini bu ortamlar üzerine ekleyip, belirli bir süre bakteri için uygun olan sıcaklıkta bekletmeniz gerekiyor. Bir zaman sonra bakteri hücresi çoğalarak koloni dediğimiz gözle görülür bir yapı oluşturuyor.
Biz de göl suyu numunesini 4 derecede 5 gün beklettiğimizde oluşan kolonileri inceledik. Bu kolonilerden aldığımız numunelere, bakterilerin hangi türe ait olduğunu tanımlamak için yapılan genetik bir testi uyguladık. Elektron mikroskobu kullanarak bakteri hücresinin yapısını inceledik. Farklı şartlar altında büyüme özelliklerini ortaya çıkardık. Daha sonra tüm DNA dizilimini inceleyerek ne tip genlere sahip olduğunu araştırdık.
HANGİ ALANLARDA KULLANILACAK?
5-) Peki, elde edilen bakteri tam olarak olarak hangi durumlarda kullanılabilecek?
Doç. Dr. Sezer Okay: İzole ettiğimiz bakterinin tüm DNA'sını analiz ettiğimizde canlı yaşamı için olumsuz şartlara dayanıklılık sağlayan genlere sahip olduğunu bulduk. En önemlisi bakterinin soğuk ortamda protein üreten genlerinin bulunuyor olması...
Ayrıca dizel yakıtlar gibi hidrokarbonların parçalanmasında görev alan genleri bulunduğunu gördük. Farklı miktarda dizel yakıt içeren ortamlarda bakterinin gelişimini incelediğimizde yüzde 5 oranında dizeli parçalayabildiğini ortaya çıkardık. Bu da bize F. aziz-sancarii bakterisinin dizel ile kirlenmiş ortamların temizlenmesinde kullanılma potansiyelini gösteriyor.
Yine laboratuvarda ağır metal içeren ortamlarda bakterinin üremesini test ettiğimizde; krom, nikel, kurşun, bakır, çinko ve kadmiyum gibi ağır metallere dirençli olduğunu gördük. Sonuç olarak, tanımladığımız bu yeni tür, ağır metal ve hidrokarbon gibi kirleticilerin bulunduğu ortamlarda yüksek sıcaklık istemeden kullanılabilecek.
Türk bilim insanları tanımladıkları bakteriye 2015 yılında Nobel Kimya Ödülü’nü alan Prof. Dr. Aziz Sancar‘ın adını verdi. Bakteri, bilimsel olarak 'Flavobacterium aziz-sancarii' olarak adlandırıldı / Fotoğraf:
NEDEN PROF. DR. AZİZ SANCAR‘IN ADI VERİLDİ?
6-) Yeni türe Prof. Dr. Aziz Sancar'ın adını verdiniz. Bu fikir nasıl ortaya çıktı?
Çiğdem Otur: Canlıların bilimsel isimlendirilmesinde tür, cins, aile gibi çeşitli sınıflar bulunur. Yeni bir canlı sınıfı tanımladığınızda bu yeni sınıfa bir isim veriyorsunuz. Fakat bu ismi verirken bazı kurallara uymanız gerekiyor. Canlının ayırt edici bir özelliği veya yaşadığı yer gibi canlıyı tanımlayan bir isim verebileceğiniz gibi bilime önemli katkılar yapmış bir insanın adını da verebiliyorsunuz.
Bizim çalışmamıza dahil olan bilim insanlarıyla yaptığımız görüşmede, yeni bir tür tanımlanması durumunda bu türe Prof. Dr. Aziz Sancar’ın adının verilmesi kararlaştırılmıştı. Bildiğiniz gibi, kendisi dünyada bilime yön veren biri... Yaptığımız çalışma yayına kabul edilince kendisine bir e-posta göndererek bilgi verdik. Çok kısa bir süre içerisinde geri dönüş yaptı. Oldukça içten ve mütevazı bir yanıt verdi. Mutlu olduğunu söyledi.
BUNDAN SONRA HANGİ ADIMLAR ATILACAK?
7-) Bundan sonraki aşamada bakteri ile ilgili atılacak adımlar neler?
Çiğdem Otur: Öncelikle yaptığımız çalışmaları makale haline getirerek, çevre kirliliği üzerine yayın yapan Chemosphere adlı dergiye sunduk. Hakem değerlendirmeleri sonucunda makalemiz yayına kabul edildi ve derginin internet sayfasında yer aldı. Yeni bakteri türlerinin kayıt altına alınması için bu türün, Uluslararası Prokaryot Sistematiği Komitesi’nin yayını olan International Journal of Systematic and Evolutionary Microbiology dergisi tarafından tanınması gerekiyor. Şu an dergiyle iletişime geçerek yeni tür adının kayıt altına alınması işlemlerini gerçekleştiriyoruz.
Türkiye son yıllarda kutuplardaki araştırmalarda git gide söz sahibi haline geliyor. Bu süreç, 2017’de Antarktika kıtasına düzenlenen ulusal bilim seferiyle başladı. Şu ana kadar altı sefer düzenlendi. 2019 yılında TÜBİTAK Marmara Araştırma Merkezi (MAM) bünyesinde Kutup Araştırmaları Enstitüsü (KARE) kuruldu. Ayrıca Antarktika’nın Horseshoe Adası’nda ülkemize ait üç adet küresel konumlandırma sistemimiz (GNSS), bir adet meteorolojik gözlem istasyonumuz ve geçici bilim kampımız bulunuyor.
Türk bilim insanları, Antarktika’da bulunan Ardley Adası’ndan alınmış göl suyu numunesinde yeni bir bakteri türü tanımladı.
İnsanlar, tarih boyunca bakteri ve virüslerle birlikte yaşadı; yaşamaya da devam ediyor.
İklim değişikliği sonucunda binlerce yıldır donmuş topraklar ve buzullar erimeye başladığı için bugün eski virüs ve bakterilerin yeniden canlanması ya da adı daha önce duyulmamış bakterilerin ortaya çıkma ihtimali oldukça yüksek. Bu nedenle dünyadaki pek çok bilim insanı kutuplarda araştırmalar yapıyor.
Son olarak Samsun Ondokuz Mayıs Üniversitesi’nden Doç. Dr. Aslıhan Kurt Kızıldoğan ve doktora öğrencisi Çiğdem Otur ile Hacettepe Üniversitesi’nden Doç. Dr. Sezer Okay, Antarktika’daki Ardley Adası’ndan alınmış olan göl suyu numunesinde yeni bir bakteri türü tanımladı.
Bakteriye 2015 yılında Nobel Kimya Ödülü’nü alan Prof. Dr. Aziz Sancar‘ın adı verildi.
Biz dünya üzerindeki bakteri ve virüslerin yol açtığı bazı hastalıklara karşı biz bağışıklık geliştirirken onlar da yeni bulaşma yöntemleri bulmayı sürdürüyor. Örneğin yüz yıl kadar önce İskoç bakteriyolog Alexander Fleming, ilk antibiyotiği (penisilin) bulduğundan beri tedavi amaçlı antibiyotik kullanıyoruz. Buna karşılık bakteriler de antibiyotiğe karşı direnç geliştirecek şekilde evrimleşiyor.
KİRLETİCİLERİN BULUNDUĞU ORTAMLARDA KULLANILABİLİR
Bakterinin DNA’sını analiz ettiklerinde pek çok şeye direnç sağladığını bulduklarını söyleyen Doç. Dr. Okay, şu detayların altını çizdi:
-- İzole ettiğimiz bakterinin canlı yaşamı için olumsuz şartlara dayanıklılık sağlayan genlere sahip olduğunu gördük. Soğuk ortamda protein üreten genleri bulunuyor. Dahası farklı miktarda dizel yakıt içeren ortamlarda bakterinin gelişimini incelediğimizde yüzde 5 oranında dizeli parçalayabildiğini de tespit ettik.
-- Ayrıca birçok antibiyotiğe karşı dirençte rol alan çok sayıda geni de barındırıyor. Özetle tanımladığımız bu yeni tür, ağır metal ve hidrokarbon gibi kirleticilerin bulunduğu ortamlarda yüksek sıcaklık istemeden kullanılabilecek.
Peki, bu bakteri nasıl keşfedildi? Bundan sonraki süreçte nasıl adımların atılması bekleniyor? Konuyu çalışmayı yürüten üç uzmanla masaya yatırdık.
KUTUPLARDAKİ BAKTERİLER İLERİSİ İÇİN HANGİ MESAJLARI VERİYOR?
1-) Son yıllarda Antarktika'dan getirilen örnekler üzerinde yapılan araştırmaların sayısı arttı. İki yıl kadar önce yine bir grup Türk bilim insanı, tarım alanında kullanılabilecek bir bakteri türü keşfettiklerini duyurmuştu. Şimdi de siz yeni bir bakteri türünü tanımladınız. Antarktika’daki bu çalışmalar ve ortaya çıkan bakterileri nasıl yorumlamak gerekiyor?
Doç. Dr. Aslıhan Kurt Kızıldoğan: Antarktika’ya yapılan seferlerde Türkiye Bilimsel ve Teknolojik Araştırma Kurumu (TÜBİTAK) tarafından desteklenen fiziki bilimler, canlı bilimleri, sosyal bilimler ve yer bilimleri gibi alanlarda çok çeşitli çalışmalar yürütülüyor.
Bu çalışmalar kapsamında; buzul değişiminin izlenmesi, küresel iklim değişikliğinin izlenmesi, kıyı çizgisinin belirlenmesi gibi araştırmaların yanı sıra deniz canlıları ve mikroorganizmalar gibi o bölgenin biyoçeşitliliğini araştıran projeler de yapılıyor. Biyoçeşitlilik çalışmaları kapsamında izole edilmiş bakteriler var. Bu bakterilerin öne çıkan özelliklerini ortaya çıkararak bu özelliklerden faydalanmaya çalışıyoruz.
2020’de İTÜ Kutup Araştırmaları Uygulama ve Araştırma Merkezi öncülüğünde de bir bakteri tanımlandı. Arktik'ten getirilen örnekler üzerinde yapılan çalışmada amaçlanan; tarımda yaygın kullanılan ve toprak kirlenmesine neden olan zehirli kimyasal bir maddeyi daha az zararlı hale getiren bir bakterilerin tanımlanmasıydı… Başarılı bir sonuç alındı. Tarımsal üretimde istenmeyen bitkileri yok etmek için kullanılacak bir bakteri türü ortaya çıkarıldı.
BAKTERİYLE İLGİLİ ÇALIŞMALAR NE ZAMAN BAŞLADI?
2-) Bakterinin keşif süreci nasıl gelişti?
Doç. Dr. Aslıhan Kurt Kızıldoğan: Ocak-Mart 2019 tarihlerinde gerçekleştirilen üçüncü Türk Antarktika Seferi’ne katılan Karadeniz Teknik Üniversitesi’nden Prof. Dr. Ersan Başar, farklı projelerden araştırmacılar için numuneleri temin etti ve bu numunelerden ilgili olanları Ondokuz Mayıs Üniversitesi’ne iletti. Ardından da çalışmalara dahil olduk.
BULUNAN BAKTERİ HANGİ TÜRE AİT?
3-) Bakterinin türü tam olarak nedir?
Doç. Dr. Sezer Okay: Tür olarak ‘Flavobacterium’ cinsine benziyor. Flavobakteriler, toprakta ya da sularda bulunan ve bazı türleri tatlı su balıklarında hastalığa sebep olan bir bakteri sınıfı. Ancak insanlara üzerinde bilinen bir zararları yok.
Bizim izole ettiğimiz bakteri üzerinde yaptığımız genetik ve biyokimyasal testler bu bakterinin Flavobacterium cinsine ait olduğunu ancak bu cins içinde şu ana kadar tanımlanmış türlerden farklılıklar gösterdiğini ortaya koydu. Tür gruplaması daha spesifik bir tanımlama olduğu için aynı türe ait olan canlıların daha büyük oranda birbirine benzemesi gerekiyor. Bizim izole ettiğimiz bakteriye tür düzeyinde benzeyen başka bir tür olmadığını tespit ettik.
Bakterinin taramalı elektron mikroskobu görüntüsü...
ÇALIŞMA NASIL İLERLEDİ?
4-) Araştırmanızda hangi aşamalardan geçerek bu sonuca ulaşıldı?
Doç. Dr. Sezer Okay: Bakterilerin üremesi için kullandığımız çeşitli besin ortamları bulunuyor. Göl suyu numunesini bu ortamlar üzerine ekleyip, belirli bir süre bakteri için uygun olan sıcaklıkta bekletmeniz gerekiyor. Bir zaman sonra bakteri hücresi çoğalarak koloni dediğimiz gözle görülür bir yapı oluşturuyor.
Biz de göl suyu numunesini 4 derecede 5 gün beklettiğimizde oluşan kolonileri inceledik. Bu kolonilerden aldığımız numunelere, bakterilerin hangi türe ait olduğunu tanımlamak için yapılan genetik bir testi uyguladık. Elektron mikroskobu kullanarak bakteri hücresinin yapısını inceledik. Farklı şartlar altında büyüme özelliklerini ortaya çıkardık. Daha sonra tüm DNA dizilimini inceleyerek ne tip genlere sahip olduğunu araştırdık.
HANGİ ALANLARDA KULLANILACAK?
5-) Peki, elde edilen bakteri tam olarak olarak hangi durumlarda kullanılabilecek?
Doç. Dr. Sezer Okay: İzole ettiğimiz bakterinin tüm DNA'sını analiz ettiğimizde canlı yaşamı için olumsuz şartlara dayanıklılık sağlayan genlere sahip olduğunu bulduk. En önemlisi bakterinin soğuk ortamda protein üreten genlerinin bulunuyor olması...
Ayrıca dizel yakıtlar gibi hidrokarbonların parçalanmasında görev alan genleri bulunduğunu gördük. Farklı miktarda dizel yakıt içeren ortamlarda bakterinin gelişimini incelediğimizde yüzde 5 oranında dizeli parçalayabildiğini ortaya çıkardık. Bu da bize F. aziz-sancarii bakterisinin dizel ile kirlenmiş ortamların temizlenmesinde kullanılma potansiyelini gösteriyor.
Yine laboratuvarda ağır metal içeren ortamlarda bakterinin üremesini test ettiğimizde; krom, nikel, kurşun, bakır, çinko ve kadmiyum gibi ağır metallere dirençli olduğunu gördük. Sonuç olarak, tanımladığımız bu yeni tür, ağır metal ve hidrokarbon gibi kirleticilerin bulunduğu ortamlarda yüksek sıcaklık istemeden kullanılabilecek.
Türk bilim insanları tanımladıkları bakteriye 2015 yılında Nobel Kimya Ödülü’nü alan Prof. Dr. Aziz Sancar‘ın adını verdi. Bakteri, bilimsel olarak 'Flavobacterium aziz-sancarii' olarak adlandırıldı / Fotoğraf:
NEDEN PROF. DR. AZİZ SANCAR‘IN ADI VERİLDİ?
6-) Yeni türe Prof. Dr. Aziz Sancar'ın adını verdiniz. Bu fikir nasıl ortaya çıktı?
Çiğdem Otur: Canlıların bilimsel isimlendirilmesinde tür, cins, aile gibi çeşitli sınıflar bulunur. Yeni bir canlı sınıfı tanımladığınızda bu yeni sınıfa bir isim veriyorsunuz. Fakat bu ismi verirken bazı kurallara uymanız gerekiyor. Canlının ayırt edici bir özelliği veya yaşadığı yer gibi canlıyı tanımlayan bir isim verebileceğiniz gibi bilime önemli katkılar yapmış bir insanın adını da verebiliyorsunuz.
Bizim çalışmamıza dahil olan bilim insanlarıyla yaptığımız görüşmede, yeni bir tür tanımlanması durumunda bu türe Prof. Dr. Aziz Sancar’ın adının verilmesi kararlaştırılmıştı. Bildiğiniz gibi, kendisi dünyada bilime yön veren biri... Yaptığımız çalışma yayına kabul edilince kendisine bir e-posta göndererek bilgi verdik. Çok kısa bir süre içerisinde geri dönüş yaptı. Oldukça içten ve mütevazı bir yanıt verdi. Mutlu olduğunu söyledi.
BUNDAN SONRA HANGİ ADIMLAR ATILACAK?
7-) Bundan sonraki aşamada bakteri ile ilgili atılacak adımlar neler?
Çiğdem Otur: Öncelikle yaptığımız çalışmaları makale haline getirerek, çevre kirliliği üzerine yayın yapan Chemosphere adlı dergiye sunduk. Hakem değerlendirmeleri sonucunda makalemiz yayına kabul edildi ve derginin internet sayfasında yer aldı. Yeni bakteri türlerinin kayıt altına alınması için bu türün, Uluslararası Prokaryot Sistematiği Komitesi’nin yayını olan International Journal of Systematic and Evolutionary Microbiology dergisi tarafından tanınması gerekiyor. Şu an dergiyle iletişime geçerek yeni tür adının kayıt altına alınması işlemlerini gerçekleştiriyoruz.
Türkiye son yıllarda kutuplardaki araştırmalarda git gide söz sahibi haline geliyor. Bu süreç, 2017’de Antarktika kıtasına düzenlenen ulusal bilim seferiyle başladı. Şu ana kadar altı sefer düzenlendi. 2019 yılında TÜBİTAK Marmara Araştırma Merkezi (MAM) bünyesinde Kutup Araştırmaları Enstitüsü (KARE) kuruldu. Ayrıca Antarktika’nın Horseshoe Adası’nda ülkemize ait üç adet küresel konumlandırma sistemimiz (GNSS), bir adet meteorolojik gözlem istasyonumuz ve geçici bilim kampımız bulunuyor.
Anadolu Ajansı (AA), İhlas Haber Ajansı (İHA), Demirören Haber Ajansı (DHA) ve diğer ajanslar tarafından eklenen tüm haberler, sitemizin editörlerinin müdahalesi olmadan ajans kanallarından çekilmektedir. Bu haberlerde yer alan hukuki muhataplar haberi geçen ajanslar olup sitemizin hiç bir editörü sorumlu tutulamaz...
Habere ifade bırak !
Bu habere hiç ifade kullanılmamış ilk ifadeyi siz kullanın.
Habere ait etiket tanımlanmamış.
Okuyucu Yorumları
(0)
Yorumunuz başarıyla alındı, inceleme ardından en kısa sürede yayına alınacaktır.